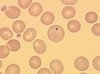

Hématologie anomalies (RT) Flashcards
Valeurs d’une anémie modérée:
70-100 g/L
Valeurs d’une anémie sévère:
< 70g/L
La plupart des signes cliniques rencontrées chez les patients anémies sont dus à 4 facteurs:
- hypoxie :diminution du transport O2
- volume sanguin diminué
- selon la vitesse ou no1 et 2 se produisent, les effets seront différents. Plus vite = plus significatif
- la facon dont le corps s’adapte au changement
Comment les globules rouges vont s’adapter à une anémie et compenser pour un manque d’O2:
- le 2-3 DPG va augmenter
- l’hémoglobine à moins d’affinité pour l’O2
- libère plus d’O2 dans les tissus
- la courbe de dissociation se déplace donc vers la droite
Quels sont les signes d’anémies dans les cas extrêmes:
- coma anémique: pas d’oxygénation
- arrêt cardiaque: quand l’hémoglobine <30g/L
Quels sont les signes cliniques de l’anémie:
- paleur: volume sanguin diminue
- asthénie (manque d’énergie): hypoxie
- tachycardie (coeur bat rapidement au repos ou moindre effort): oxygénation des tissus
- polypnée (accélération de la respiration): oxygénation des tissus
- dyspnée (difficulté à respirer au repos): manque d’oxygène aux poumons
- céphalée: manque d’oxygène
- vertige: manque d’oxygène
- bourdonnement d’oreille
- fatigue intense pour effort modéré: manque d’O2, nutriments et fer
- perte d’apétit
- fièvre
Anémie régénérative:
Les rétics augmentent
Anémie agénérative:
Rétics diminuent
Quel est le cycle évolutif de la malaria:
- l’anophèle femelle pique un humain infectée. Le sang contient les gamétocytes
- le gamétocyte femelle est fertilisé dans l’estomac de l’anophèle pour donner naissance au zygote
- le zygote se développe pour former un oocyte
- l’abdomen de l’anophèle grossit et libère les sporozoaires qui migrent dans les glandes salivaires du moustique
- lorsque l’anophèle pique un humain, elle lui injecte les sporozoaires dans le sang
- les sporozoaires envahissent les cellles du foie et le cycle schizogonique exo-érythrocytaire commence
- les cellules hépatiques rompent et relâchent les parasites (mérozoites) qui reviennent dans le sang se fixant sur les globules rouges. Le cycle schizogonique érythrocytaire commence
- le parasite devient un trophozoite jeune qui apparait sous forme d’anneau
- il devient un trophozoite agé qui apparait comme un anneau avec un cytoplasme plus ou moins amiboide
- division schizogonique du trophozoite commence, qui entraine la formation du schizonte
Le paludisme peut être plusieurs types de maladie hémolytique:
- aigue
- chronique
- à fièvre récurrente
Où se développe la malaria chez l’humain:
Premièrement dans le foie, ensuite dans le sang et les organes.
Comment se fait le diagnostic de la malaria:
Mise en évidence du parasite au microscope à partir d’un frottis de sang coloré au Giemsa:
- frottis épais
- frottis mince
- goutte de sang
Comment identifie-on l’espèce de malaria:
- morphologie
- corps d’inclusions
- Zieman (malariae)
- Maurer (falciparum)
- Schuffner (vivax et ovale)
Quels sont les symptomes les plus fréquents de la malaria:
- forte fièvre
- frissons
Quelle espèce de malaria présente une anémie peu importante dans la fièvre quarte:
Plasmodium malariae
Quelle espèce de malaria présente une anémie modérée dans la fièvre tierce bénigne:
Plasmodium vivax et ovale
Quelle espèce de malaria présente une anémie très grave dans la fièvre tierce maligne:
Plasmodium falciparum
Pourquoi la CGMH est normale dans l’anémie macrocytaire:
Car la quantité d’hémoglobine est proportionnelle à la grosseur
Pourquoi la TGMH est augmenté dans l’anémie macrocytaire:
Parce que le VGM est augmenté, en cause le poids du GR est augmenté.
Comment reconnait-on l’anémie macrocytaire:
- VGM augmente
- TGMH augmente
- CGMH normal
Qu’est ce qu’un mégaloblaste:
Grosse cellule avec asynchronisme de maturité entre le noyau et le cytoplasme.
Quel est le problème dans les anémies mégaloblastiques:
Il y a insuffisance de globules rouges adultes car il y aun manque de matériaux essentiels à leur production
Pourquoi la moelle est quand même hypercellulaire dans l’anémie mégaloblastique:
Car l’érythropoièse est inefficace mais la moelle essaye de compenser.
Pourquoi y-a-til une pancytopénie durant les anémies mégaloblastiques:
Les GR, plt et GB sont détruits dans la moelle.
Globules blancs
4.8-10.8 X 109/L
Hématocrite:
Adulte (M): 0.420-0.520 L/L
Adulte (F): 0.370-0.470 L/L
Nouveau-née: 0.450-0.670 L/L
Enfant: 0.300-0.430 L/L
VGM:
80-100 fL
TGMH:
27-31 pg
CGMH:
320-360 g/L
Différentiel (valeurs relatives):
Basophiles 0-2%
Éosinophiles 0-4%
Stabs 2-6%
Monocytes 2-9%
Lymphocytes 20-44%
Neutrophiles 50-70%
Réticulocytes (valeurs relatives)
Adulte 0.5-2.0%
Nouveau-née 2.5-6.0%
Vitesse de sédimentation:
Adulte (M) 0-15 mm/hr
Adulte (F) 0-20 mm/hr
TQ
11.0-13.0 sec
INR thérapeutique:
2.0-3.0
INR sans-anticoagulant:
INR (valeur critique):
>= 5.0
Plaquettes:
150-400 X 109/L
Globules rouges:
Adulte (M) 4.7-6.1 X 1012/L
Adulte (F) 4.2-5.4 X 1012/L
Nouveau-née 4.3-6.3 X 1012/L
Hémoglobine:
Adulte (M): 140-180 g/L
Adulte (F): 120-160 g/L
Nouveau-née: 140-220 g/L
Anémie:
Adulte (M):
Adulte (F):
Différentiel (valeurs absolues):
Basophiles: 0-0.2 X 109/L
Éosinophiles: 0-0.5 X 109/L
Stabs: 0-0.7 X 109/L
Monocytes: 0.11-0.59 X 109/L
Lymphocytes: 1.2-3.4 X 109/L
Neutrohpiles: 1.4-6.5 X 109/L
Réticulocytes (valeurs absolues):
24-84 X 109/L
TCA:
30.0-40.0 secondes
Temps de saignement:
2.5-9.5 minutes
Temps de thrombine:
15-22 secondes
Temps de reptilase:
18-22 secondes
Quels sont les trois membranes du cerveau:
- externe et plus résistante: dure-mère
- au milieu: arachnoide
- surface du cerveau: pie-mère
Par quoi est produit le LCR au niveau des ventricules cérébraux:
Plexus choroide
Par quelles cellules est produit le LCR:
Épendymère
Où circule le LCR:
Espaces sous-arachnoides
Qu’est ce qui réabsorble le LCR:
Villosités arachnoidiennes
Le prélèvement du LCR est effectué où:
entre la 3e et 4e vertèbre
Quels sont les rôles du LCR:
- coussin pour SNC, protège contre les pressions et les chocs
- milieu d’échange entre le sang et le cerveau
- maintient la pression intracrânienne constante
Quel est le volume de LCR chez un adulte:
90-150 ml
Quel est le volume de LCR chez un enfant:
60-90 ml
Quel est le volume de LCR chez un nouveau-né:
10-60 ml
Le renouvellement constant du LCR est de combien:
500ml/jour
20ml/heure
Qu’est ce qui indique un LCR turbide:
- bactéries
- GB > 200
- protéines
- GR > 400
Quelle est la cause la plus commune de présence de neutro/bactéries:
Méningite bactérienne
Qu’est ce qui cause la présence de sang dans le LCR:
- ponction traumatique: plus de sang dans le premier tube et diminue progressivement
- hémorragie récente: même quantité de sang dans tous les tubes
Quelle couleur est le LCR s’il est xantochromique:
Jaune surtout, rouge-orange après centrifugation
Quelle est l’ordre des départements avec l’ordre des tubes pour le LCR:
- biochimie
- microbiologie
- hématologie
La xantochromie du LCR est causée comment:
- après une hémorragie intracranienne, il y a hémolyse des GR et libération d’oxyhémoglobine (2-3h)
- dans 24 heures, l’hémoglobine des GR lysés convertit en bilirubine qui donne une couleur jaune
La présence de beaucoup de neutrophiles avec des macrophages dans le LCR indique quoi:
Une inflammation
L’augmentation des neutrophiles dans le LCR démontre:
Typiquement une méningite bactérienne mais aussi le début de méningite virale, tuberculeuse ou fongique.
On retrouve beaucoup de lymphocytes dans le LCR dans quelle condition:
méningite virale
Un grand nombre de basophiles dans le LCR indique quoi:
condition inflammatoire
Un grand nombre d’éosinophiles dans le LCR indique quoi:
Infection parasitaire ou fongique réaction allergique, méningite idiopathique à éosinophiles.
On retrouve des plasmocytes dans le LCR dans quelle condition:
- maladie Hodgkin
- méningoencéphalite
- tuberculose
- sarcoidase
- syphillis
- sclérose en plaque
Deux heures après le prélèvement du LCR, quel pourcentage de GB seront détruites:
40%
Deux heures après le prélèvement du LCR, quel pourcentage des GB seront détruite à 4oC:
15%
Qu’est ce qui donne la charge négative de la membrane érythrocytaire :
l’acide sialique.
Concentration du sodium et du potassium dans les globules rouges:
- La concentration du sodium dans le globule rouge est 12 fois inférieure à celle du plasma.
- La concentration du potassium est 25 fois plus élevée à celle du plasma.
Qu’est ce qui se passe lorsque l’aTP est fournie en quantité insuffisante :
- le mouvement des ions ne peut pas être régulé.
- Il y aura donc modification de la pression osmotique du globule rouge
- L’érythrocyte perdra ainsi sa forme biconcave et deviendra sphérique
- Il sera éliminé de la circulation par les cellules du système réticulohistiocytaire dans la rate.
Le glucose fourni par le plasma et présent dans le globule rouge est catabolisé de deux façons
- Par glycolyse anaérobie grâce au cycle d’Embden-Meyerhof : de 90-95 % du glucose présent.
- Par la voie des pentoses ou celle des hexoses phosphates : de 5-10% du glucose présent
Le globule rouge a besoin d’énergie pour :
- Conserver le fer de l’hémoglobine sous la forme de fer bivalent, capable de fixer l’oxygène
- Maintenir l’équilibre sodium-potassium dans la cellule
- Prévenir l’oxydation de ses composants comme l’hémoglobine et les enzymes
- Conserver sa forme biconcave, laquelle assure une grande surface de diffusion à l’oxygène et facilite sa circulation dans les petits vaisseaux
Durée de vie moyenne des globules rouges:
120 jours et 0.8-1% des globules rouges de la circulation sont remplacés quotidiennement.
Pourquoi le globule vieillie rapidement :
la cellule est incapable de renouveler son bagage enzymatique, ce qui rend le globule rouge inapte à produire l’énergie nécessaire à sa survie.
Les principales anomalies liées au vieillissement érythrocytaire
- Diminution des lipides contenus dans la membrane
- Perte de l’acide sialique de la membrane, donc moins flexible
- Sphérocytose, diminution du volume globulaire et augmentation de la concentration en hémoglobine.
- Diminution du gradient osmotique
- Augmentation de la méthémoglobine et de l’hémoglobine dénaturée (corps de Heinz)
- Diminution de l’activité enzymatique du cycle de dégradation du glucose
- Augmentation des fragilités osmotique et mécanique, donc détruite plus facilement.
Il y a trois différentes sortes d’hémolyse :
- Hémolyse osmotique : Quand les g.r sont dans un milieu hypotonique (↓Na Cl) ils absorbent plus de liquide jusqu’a ce qu’ils brisent et libèrent l’hgb.
- Hémolyse par altération physique : Quand quelque chose change physiquement la cellule, la rend moins résistante à l’hémolyse osmotique et mécanique. La cellule doit être capable de se déformer pour pouvoir passer partout où elle a besoin, donc si elle est moins résistante, son habilité de subir ces changements diminue.
- Hémolyse chimique : Différents produits peuvent hémolyser le g.r. :
- acide gras
- lécitine
- saponine
- Anticorps, avec l’aide du complément, comme dans la réaction transfusionnelle
Où la phagocytose se produit :
dans la rate (principalement), le foie et la moelle osseuse.
Proportion de la destruction des globules rouges :
- 80-90% des globules rouges sont enlevés de la circulation par phagocytose, donc pas d’hémolyse vasculaire.
- 10-20% de la destruction normale est intravasculaire
La phagocytose se produit selon certaines étapes :
- Adhérence : le g.r. se colle au phagocyte
- Ingestion : le cytoplasme de la cellule macrophage entoure le g.r.
- Formation de la vacuole de phagocytose.
- Digestion : la cellule macrophage peut « expulser » des restes de la digestion.
- *Stroma : décomposé dans le cytoplasme
- *Fer : réutilisé par les érythroblastes
- *Globine: détruite, AA réutilisés
- *Noyau de l’hème : transformé en bilirubine
Corps de Jolly

Corps de Pappenheimer

Corps de Heinz

Anneau de Cabot

Ponctuations basophiles
Présence d’érythrocytes de couleurs différentes:
Anisochrome
Présence de globules rouges basophiles:
Polychromatophilie
Érythrocytes de diamètre diminué:
Microcytose
Présence d’érythrocytes de teinte plus pâle que normalement:
Hypochromie
Présence d’érythrocytes de formes variables:
Poikilocytes
Présence de globules rouges dont le centre et la périphérie est bien colorée:
Codocytes
Fragments de globules rouges brisés:
Schistocytes
Globule rouge en feuilles d’acanthes:
Sélénocytes
Globule rouge en ellipse ou en cigare:
Elliptocytes
Présence d’érythrocytes de tailles franchement différentes:
Anisocytose
Érythrocyte de très grande taille, caractéristgique de l’anémie de Biermer:
Mégalocyte
Globule rouge plat dont l’hémoglobine se dépose à la périphérie:
Leptocyte
Globule rouge ayant la forme de faucille:
Drépanocytes
Globule rouge ayant un ou plusieurs spicules:
Acanthocytes
Érythrocytes de diamètre augmenté:
Macrocytose
Propriété qu’ont les globules rouges de s’accoler les uns aux autres:
Rouleaux
Érythrocyte avec de courts spicule disposés régulièrement:
Échinocytes
Globule rouge foncé plus petit que normalement:
Sphérocyte
Globule rouge ayant la forme d’une bouche:
Stomatocyte
Érythrocyte en forme de larme:
Dacryocyte
Présence de GR de diamètre augmenté avec un volume globulaire moyen augmenté:
Macrocytose
GR avec spicules de longueur variable disposés irrégulièrement:
Acanthocytes
GR foncées plus petits que normalement avec un volume globulaire moyen à la limite inférieure normale et une concentration globulaire moyenne en hémoglobine augmentée:
Sphérocyte
Petits corps sphériques bleus très foncés situés à la périphérie du globule rouge et visible à la coloration Giemsa.
Corps de Jolly
Présence de GR de formes franchement différentes:
Poikilocytose
Fines granulations bleues dont le nombre et la taille sont variables et qui sont réparties sur toute la surface du globule rouge:
Ponctuations basophiles
Présence de globules rouges ayant une intensité variable dans la coloration:
Anisochromie
Érythrocytes plats où l’hémoglobine est disposée en périphérie:
Annulocytes
Corps provenant de la dénaturation de l’hémoglobine:
Corps de Heinz
Fragments de noyau (ADN):
Corps de Jolly
Corps provenant de la dénaturation de l’hémoglobine:
Corps de Heinz
Restes nucléaires après fragmentation du noyau:
Corps de Jolly
Fibres provenant du fuseau mitotique:
Anneaux de cabot
Grains de fer:
Corps de Pappenheimer
Granulations provenant de l’agrégation anormale de l’ARN:
Ponctuations basophiles
Mis en évidence par la coloration au bleu de Prusse:
Corps de pappenheimer
Mis en évidence par les colorants vitaux seulement:
Corps de Heinz
Présents dans le réticulocyte lors de la malaria à plasmodium vivax:
Corps de schuffner
Présents dans le globule infesté par le plasmodium falciparum:
Corps de maurer
Fil fin en anneau ou en huit rouge violacé:
Anneaux de cabot
Petit corps sphériques bleu foncé:
Corps de Jolly
Petits points bleus groupés par trois:
Pappenheimer
Fine granulations bleues:
Ponctuation basophile
Petits grains rouge vif:
Schuffner
Granulations irrégulières bleu pourpre:
Corps de Heinz
Poussière pourpre:
Ponctuation basophile
Grosses granulations irrégulières violet gris (malaria):
Corps de Zieman
Les corps de Jolly sont ils visibles à la coloration Giemsa:
Oui
Les corps d’Auer sont ils visibles à la coloration Giemsa:
Oui
Les corps de Dohle sont ils visibles à la coloration Giemsa:
Oui
Les corps de Russell sont ils visibles à la coloration Giemsa:
Oui
Les corps de Pappenheimer sont ils visibles à la coloration Giemsa:
Oui
Les corps de Heinz sont ils visibles à la coloration Giemsa:
Non
Les anneaux de cabot sont ils visibles à la coloration Giemsa:
Oui
Les granulations toxiques sont ils visibles à la coloration Giemsa:
Oui
La chromatine sexuelle sont ils visibles à la coloration Giemsa:
Oui
Les corps de Schuffner sont ils visibles à la coloration Giemsa:
Oui
Les corps de Alder-Reilly sont ils visibles à la coloration Giemsa:
Oui
Les corps de Barr sont ils visibles à la coloration Giemsa:
Oui
Les ponctuations basophiles sont ils visibles à la coloration Giemsa:
Oui

Corps d’Auer
Corps de Dohle

Corps de Russell

Granulations toxiques

Chromatine sexuelle

Corps de Barr
Courbe de dissociation vers la droite:
- affinité de l’hémoglobine pour l’oxygène diminue
- l’oxygénation des tissus est meilleure
- augmentation du 2,3 DPG
Courbe de dissociation vers la gauche:
- l’affinité de l’hémoglobine pour l’oxygène est augmentée
- l’oxygénation des tissus est moins bonne
- diminution du 2,3 DPG
Fraction protéique de l’hémoglobine:
Globine
Groupement prosthétique de l’hémoglobine:
Hème
Hémoglobine A1:
alpha2bêta2
Carboxyhémoglobine:
Hb + CO
hémoglobine foetale:
alpha2gamma2
Carbhémoglobine:
Hb + CO2
Méthémoglobine:
Fer à l’état ferrique
Haptoglobine:
Protéine capable de fixer l’hémoglobine plasmatique
Transport du fer plasmatique:
Sidérophiline
Réserves de fer facilement disponible:
Ferritine
Fer de l’hème:
Fer à l’état ferreux
Méthémoglobine:
Fer à l’état ferrique
Apoferritine:
Protéine constituante de la ferritine
Réserves de fer moins disponibles
Hémosidérine
Synonyme de sidérophiline:
Transferrine
Molécule où est fixé le fer:
Hème
Où se fait l’absorption du fer:
Au duodénum
Perte moyenne de fer par jour:
1mg/jour
Quantité de fer dans l’organisme:
3-5g
Comment on fait l’évaluation des réserves de fer:
Avec la coloration au bleu de Prusse
Modifications des globules rouges lors d’une carence en fer:
Microcytose et hypochromie
Hémosidérose:
Accumulation de fer dans l’organsime
Agrégats de réticulum endoplasmitque:
Corps de Dohle
Vacuoles composées de mucopolysaccharides et de gamma-globulines:
Corps de Russelll
Grosses granulations violet pourpre dans le granulocyte neutrophile lors d’états infectieux aigus:
Granulations toxiques
Inclusions rouge pourpre souvent rencontrés dans les leucémies myéloblastiques:
Corps d’Auer
Vacuoles de taille variable trouvées dans les plasmocytes:
Corps de Russell
Appendice nucléaire rattaché au noyau du granulocyte neutrophile par un fin filament de chromatine:
Chromatine sexuelle
Amas de chromatine en forme de triangle trouvé seulement sur la membrane nucléaire des individus de sexe féminin:
Corps de Barr
Zones bleus à la périphérie du cytoplasme du granulocyte neutrophile lors d’états infectieux aigus:
Corps de Dohle
L’hémoglobine est composée de quoi:
- globine: fraction protéique
- hème: groupement prosthétique (molécule organique non-protéique)
L’hème est composée de quoi:
- protoporphyrine
- fer
Quelle est la structure de l’hème:
- 4 noyaux pyrroles
- 8 chaines latérales
- 2 vinyles
- 2 propionyles
Chaque molécule d’hème est capable de lier:
Une molécule d’oxygène de facon réversible
La globine est constituée de:
Deux paires de chaines polypeptidiques
Combien d’acides aminés ont les chaines d’hémoglobine:
- alpha: 141 acides aminés
- les autres: 146 acides aminés
Les acides aminés sont unis par:
Liaisons peptidiques
Structure primaire:
La séquence d’acide aminé qui est réunis par des liaisons peptidiques.
Structure secondaire:
- structure hélicoidale stabilisée par des liaisons hydrogènes
- c’est la chaine polypeptidiques qui s’enroule sur elle-même
- elle est faite de 8 segments hélicoidaux rattachés par des petits segments non hélicoidaux
- chaque segment est identifié par une lettre, de A à H
Structure tertiaire:
Les 8 segments sont repliés et forment une molécule tridimensionnelle de forme sphéroide stabilisée par des forces hydrophobes.
Où est inséré la molécule d’hème:
Entre l’hélice E et F
Structure quaternaire:
La combinaison des 4 chaines polypeptidiques s’ajuste pour former une molécule globulaire symétrique.
Quelle structures sont pareilles pour toutes les chaines polypeptidiques normales de la globine:
Structure tertiaire et quaternaire
Liaison entre alpha1bêta1 et alpha2bêta2
Les liaisons sont fortes et stables, il y a contact de 34 acides aminés.
Liaison entre alpha1bêta2 et alpha2bêta1:
Les liaisons sont plus lâches, il y a contact de 19 acides aminés.
Où se trouve la molécule 2,3 DPG:
Dans la cavité centrale de la molécule d’hémoglobine désoxygéné. Il est fixé aux chaines bêta.
La présence de 2,3 DPG favorise quoi:
La libération de l’oxygène dans les tissus.
Endroit de la synthèse de l’hème:
- 85% est synthétisé dans les érythroblastes de la moelle osseuse
- 15% est synthétisé surtout au foie
Quel organite est important dans la biosynthèse de l’hème :
les mitochondries.
Où les étapes de la synthèse de l’hème se font :
les premières et les dernières se font dans les mitochondries. Les étapes intermédiaires se font dans le cytosol.
Pourquoi les globules rouges adultes ne participent pas à la synthèse de l’hème :
parce qu’au fur et à mesure que la cellule mature, les mitochondries se dégradent.
Quelle synthèse est synchronisée :
la synthèse de l’hème et la synthèse de la globine
Quelles synthèses ne sont pas synchronisées :
le fer et la globine. Quand la production de globine diminue, le fer s’accumule dans les cellules sous forme de ferritine.
Quels chromosomes sont responsables de la biosynthèse de l’hème :
- Chromosome 16 est responsable des chaines alpha et zêta
- Le chromosome 11 est responsable des chaines bêta, delta, gamma et epsilon
La biosynthèse de la globine suit le schéma général de la synthèse des protéines :
- Elle dépend de l’ARN
- Elle se situe dans les ribosomes
Hémoglobine anormale :
hémoglobines qui ont des modifications de structure d’une chaine de la globine.
Une hémoglobine anormale est le plus souvent causé par :
une mutation de gène qui va causer une substitution d’un acide aminé pour un autre.
Où sont fait les substitutions des acides aminés :
surtout sur les chaines alpha et beta.
Deux sortes d’affections causées par des anomalies de l’hémoglobine :
- Anomalies de structure des chaines de la globine
- Anomalies de synthèse des chaines de la globine, où une des chaines est insuffisante et l’autre augmente pour compenser
Quel est le problème avec les pigments anormaux :
Ils sont incapables de fixer l’oxygène, donc produit une hypoxie tissulaire en grande quantité.
La cyanose (couleur bleue de la peau et de muqueuses) dépend de :
- La concentration de ces pigments ou
- La présence d’une quantité exagérée d’hémoglobine désoxygénée
Quels sont les fonctions de l’hémoglobine:
- transport de l’oxygène des poumons aux tissus
- transport du gaz carbonique des tissus aux poumons
- maintien du pH sanguin de 7.35-7.45
Saturation de l’hémoglobine en oxygène :
environ 96%, ce qui veut dire que 1.39 ml d’oxygène pour chaque gramme d’hémoglobine.
Quelle partie de l’hémoglobine qui fixe l’oxygène :
le fer
Combien de molécules d’oxygène peut fixer l’hémoglobine
l’hémoglobine a 4 atomes de fer donc chaque molécule d’hémoglobine peut fixer 4 molécules d’oxygène.
Facteurs qui influencent la dissociation de l’hémoglobine :
- Température du corps : quand la température augmente, la quantité d’oxygène libérée par l’hémoglobine augmente aussi.
- pH sanguin : quand l’acidité augmente, le pH diminue, l’affinité de l’hémoglobine pour l’oxygène diminue, donc la dissociation augmente.
- concentration sanguine en CO2 : quand la concentration sanguine augmente en CO2, la libération de l’oxygène dans les tissus augmente.
- concentration en 2,3 DPG : quand le 2,3 DPG augmente, l’affinité diminue et la dissociation augmente.
étapes de la dissociation de l’hémoglobine due à la température du corps :
- les cellules métaboliquement actives ont besoin d’une plus grande quantité d’oxygène libèrent plus d’acide et de chaleur
- l’acide et la chaleur vont favoriser la libération d’oxygène de l’oxyhémoglobine
- quand il y a hypothermie, le métabolisme cellulaire ralentit, le besoin d’oxygène diminue et une plus grande quantité d’oxygène reste liée à l’hémoglobine.
où vont les globules rouges usé ou brisé :
ils peuvent éclater mais la plupart des cellules usées vont être retirées de la circulation et détruites par des macrophages du SRH.
Composantes du catabolisme de l’hémoglobine:
- Bilirubine
- Fer : récupéré par la transferrine et réutilisé
- Globine : détruite
- Acides aminés : réutilisé
Ces facteurs vont t-il augmenter ou diminuer avec une hyperhémolyse :
Bilirubine
Taux d’hémoglobine plasmatique
Taux d’haptoglobine
Taux d’hémopexine
Méthémalbumine
- augmentation
- augmentation
- diminution
- diminution
- une présence
Augmentation de la bilirubine lors d’hyperhémolyse:
lorsqu’il y a hémolyse, l’hémoglobine est libérée et est convertie, par une série de réactions, en bilirubine.
Augmentation du taux d’hémoglobine plasmatique lors d’une hyperhémolyse :
s’il y a hyperhémolyse, l’haptoglobine qui est normalement combiné avec l’hémoglobine ne peut plus fournir, donc il y a de plus en plus d’hémoglobine qui est libre dans le plasma.
Diminution du taux d’haptoglobine lors d’une hyperhymolyse:
avec une hyperhémolyse, il y a plus d’hémoglobine de libre dans la circulation et peut donc se fixer à l’haptoglobine. Ce complexe haptoglobine-hémoglobine est éliminé de la circulation. Le taux d’haptoglobine va donc diminuer.
Diminution du taux d’hémopexine lors d’une hyperhémolyse:
avec une hyperhémolyse, il y a plus d’hème de libre dans le sang et peut donc se fixer à l’hémopexine. Ce complexe hémopexine-hème est ensuite éliminé de la circulation. Le taux d’hémopexine va donc diminuer.
Présence de méthémalbumine lors d’une hyperhémolyse:
l’albumine peut fixer l’hème pour former la méthémalbumine. Donc plus d’hème de libre dans le sang, on aura plus de chance à retrouver de la méthémalbumine. L’affinité du complexe albumine-hème est moins grande que hémopexine-hème. Ces deux complexes donnent la couleur brune du plasma.
Hémoglobinurie lors d’une hyperhémolyse:
L’hémoglobine plasmatique qui n’a pas pu se lier à l’haptoglobuline, afin de se faire éliminer par le complexe haptoglobine-hémoglobine, est éliminé par l’urine (ce qu’on nomme hémoglobinurie) quand l’hémoglobinurie est trop élever ceci peut causer une insuffisance rénal aigüe.
Hémosidérinurie lors d’une hyperhémolyse:
le fer provenant de l’hémoglobine pendant l’hémosidérinurie est réabsorbé dans les cellules du tubule rénal en dépôt de fer. L’hémosidérinurie apparait quelques jours plus tard quand les cellules desquament dans les urines.
Rôle du fer dans l’hémoglobine :
fixe l’oxygène atmosphérique et le transporte aux tissus.
Rôle du fer dans la myoglobine :
fixe l’oxygène et le transporte aux muscles.
Rôle du fer dans les cytochromes, la catalase et la peroxydase
participation constante aux réactions d’oxydoréduction pour le bon fonctionnement.
Quantité de fer chez l’homme :
50mg/kg
Quantité de fer chez la femme :
35mg/kg
quantité de fer l’hémoglobine comporte :
environ 67% du fer de l’organisme.
Quantité de fer dans le plasma :
<1%
Quantité de fer dans les muscles :
3%
Quantité de fer sous forme de réserve :
30%
- Chez l’homme : 1g
- Chez la femme : 200-400mg
Le fer existe sous deux formes :
- Fer héminique, fonctionnel
- Fer non héminique, non fonctionnel
Quels sont les fers de réserve :
ferritine et hémosidérine.
Quel est le fer de transport :
sidérophiline (transferrine).
Quantité de fer nécessaire à l’érythropoïèse chaque jour :
20-25mg ou 1mg de fer pour chaque mL de globules rouges.
L’apport et perte de fer :
0.5-1.5 mg/jour
Apport de l’alimentation en fer:
apporte de 10-30mg de fer pour en absorber environ 1 mg.
Ce qui favorise l’absorption du fer :
- vitamine C
- alcool
Ce qui diminue l’absorption du fer :
Café et thé
Un apport insuffisant en fer peut mener à :
une anémie ferriprive.
Si l’apport en fer est plus grand que les pertes :
hémosidérose ou hémochromatose.
Pertes de fer :
- Selles
- Sueur
- Urines
- Peau
- Phanères (cheveux, ongles)
Perte durant la période menstruelle
une perte additionnelle de 0.5-1.5 mg/jour
Besoins en fer durant une grossesse :
augmente à 2.5mg/jour
La perte de fer durant l’accouchement :
200mg
Fer de l’hémoglobine chez l’enfant naissant
Fer de réserves chez l’enfant naissant : 100 mg
Étapes du cycle du fer :
- La sidérophiline est une protéine qui lie le fer du plasma. Son rôle est le transport du fer donc elle le transporte à la moelle osseuse.
- Dans la moelle osseuse, le fer est utilisé pour la synthèse de l’hémoglobine.
- Après la synthèse de l’hémoglobine, les globules rouges, qui contient l’hémoglobine et donc le fer, quitte la moelle osseuse et entre dans la circulation sanguine.
- Après 120 jours, le système réticulohistiocytaire va détruire les globules rouges par les macrophages.
- Le fer est libéré
Le fer qui est libéré a deux options :
- Soit qu’il est emmagasiné dans les macrophages sous forme de ferritine ou d’hémosidérine.
- La majorité est retournée au plasma où il se lie de nouveau à la sidérophiline.
95% du fer que nous avons besoin quotidiennement à l’érythropoïèse vient de :
la dégradation de l’hémoglobine.
Fer alimentaire :
- État ferrique : sucres
- État ferreux : viandes rouges
Difficultés du fer inorganique (non héminique) :`
- Sels de fer insolubles en milieu alcalin
- Fer ferrique plus difficile à être absorbé par la paroi intestinale que le fer ferreux
Facteurs qui favorisent la solubilité et la réduction du fer inorganique facilite l’absorption :
- Acide ascorbique
- cystéine
acide chlorhydrique de l’estomac :
- stabilise le fer alimentaire non héminique
- empêche la formation d’hydroxyde ferrique
le liquide gastrique acide favorise :
- réduction du fer
- liaison du fer avec des substances solubles
absorption et régime alimentaire :
- le fer non héminique dépend du régime alimentaire
- le fer héminique ne dépend pas du régime alimentaire
comment l’absorption du fer se fait :
le noyau porphyrique libère le fer lié à l’hème à l’intérieur de la muqueuse de l’intestin.
Facteurs qui influencent le taux d’absorption :
- Les réserves de fer : l’absorption est indirectement proportionnelle aux réserves (intelligence de la muqueuse)
- Activité hématopoïétique : l’absorption est directement proportionnelle à l’hématopoïèse
La sidérophiline est synthétisée dans
le foie par le réticulum rugueux des cellules de parenchyme hépatique.
Qu’est ce qui détermine dans quel type de transferrine ils se retrouvent
la séquence de leurs acides aminés.
Taux de fer sérique chez l’homme :
22umol/L
Taux de fer sérique chez la femme :
20umol/L
Capacité total de fixation de la sidérophiline :
61umol/L
Coefficient de saturation de la sidérophiline :
20-45% (seulement 1 site sur 3 est fixé par le fer)
Renouvellement du fer :
au moins 10 fois par 24 heures.
Le fer est transporté sous forme de :
Fe3+ par les sidérophilines.
Site de fixation du fer :
sur les résidus terminaux d’histidine et de tyrosine.
Une fois dans la moelle osseuse, le fer peut soit :
- Être utilisé dans la synthèse de l’hémoglobine
- Être mis en réserve sous forme de ferritine ou hémosidérine.
L’incorporation du fer dans les érythroblastes :
- La sidérophiline permet l’incorporation du fer dans les jeunes globules rouges
- Le complexe de sidérophiline-fer se fixe sur une cellule qui peut synthétiser de l’hémoglobine.
- Ensuite le fer est libéré sur les sites de récepteur spécifique de la membrane.
- La sidérophiline qui est maintenant libérée retourne dans le plasma et le fer est incorporé à l’hème
Combien longtemps prend le processus de l’incorporation :
environ 1 heure
Où sont la majorité des réserves de fer dans l’organisme :
au niveau du foie, la rate, la moelle osseuse et l’intestin.
Deux formes de fer :
- Ferritine (soluble)
- Hémosidérine (insoluble)
Où la ferritine est-elle localisée :
dans les cellules du système réticulohistiocytaire (SRH).
Hémosidérine :
grains de fer sous forme d’oxyde ferrique
Composition de l’hémosidérine :
protéines, lipides, porphyrine.
Comment on mesure les réserves de fer :
- Avec le dosage de la ferritine sérique
- Coloration au bleu de Prusse
- Méthode isotopique
Utilité du fer chez l’érythroblaste :
synthèse de l’hémoglobine.
Sidéroblaste :
érythroblaste portant des grains de fer.
Sidéroblaste normal :
< 5 grains de fer
Si >5 grains :
sidéroblaste en couronne
Différents types de carences en fer :
- Carence absolue
- Carence relative
- Anomalie métabolique
les carences sont causées par :
- pertes plus grandes que les apports
- hémorragie chronique évidente ou cachée
- lors des grossesses rapprochés, menstruations abondantes
- défaut d’absorption ou malabsorption :
- absorption de fer est diminuée quand le transit est accéléré (diarrhées chroniques)
- maladie chronique de l’intestin grêle
- après une gastrectomie et dans l’anastomose gastrojéjunale
- certains chélateurs peuvent réduire l’absorption de fer en formant avec celui-ci des composés insolubles.
3 phases de gravité croissante (fer) :
- Diminution du fer de réserve : aucune modification qualitative ou quantitative des globules rouges
- Disparition du fer de réserve :
- Le fer sérique est abaissé, la capacité totale de fixation de la sidérophiline est augmentée et le coefficient de saturation de la sidérophiline est diminué
- Diminution du taux d’hémoglobine, la morphologie érythrocytaire et les indices globules sont peu affectés.
- Apparition d’une anémie microcytaire hypochrome :
- Les indices globulaires sont diminués et le frottis révèle de la microcytose et de l’hypochromie.
- Démontre qu’il a rareté dans la moelle osseuse
- La ferritine plasmatique et le fer sérique sont très diminués
Hémosidérose :
la surcharge en fer, non liée à un trouble de l’absorption.
L’hémosidérose est causé par :
l’ingestion excessive de fer alimentaire ou de médicament échelonnée sur plusieurs années.
Hémochromatose :
absorption exagérée du fer alimentaire.
L’hémochromatose cause :
une surcharge cellulaire diffuse avec la sclérose des tissus atteints.
Les organes touchés par l’hémochromatose sont :
d’abord le foie puis le pancréas, le cœur, les surrénales et les testicules.
Les gens ayant quoi sont atteints de l’hémochromatose :
antigène HLA-A3
Une diminution du fer entraine :
- La diminution de l’hémoglobine
- La diminution de l’hématocrite
- La diminution du nombre de GR
Coefficient de saturation de la sidérophiline :
CSS = fer sérique / capacité totale de fixation X 100
Valeur normale du CSS :
20-45%
Protoporphyrine :
molécule où une enzyme incorpore le Fe lors de la synthèse de l’hème.
Augmentation de la protoporphyrine est un indicateur :
d’anémies causées par un manque de fer.
Évaluation des réserves de fer peut se faire par :
- Le dosage de la ferritine sérique
- La coloration au bleu de Prusse
- La méthode isotopique
Pourquoi on fait le dosage pour la carence en fer :
- Dépister un déficit en fer
- Surveiller les groupes susceptibles d’avoir une carence en fer
- Assurer le suivi d’un traitement par le fer
- Distinguer les anémies microcytaires hypochromes par déficit en fer des autres anémies microcytaires hypochromes.
Pourquoi on fait le dosage pour la surcharge en fer :
- Diagnostiquer ou dépister l’hémochromatose
- Assurer le suivi du traitement de l’hémochromatose
- Surveiller des hémodialysées
- Surveiller des multi transfusée
Leur nombre doit être supérieur à quoi pour être nommé une leucocytose :
10.0X109/L
Leur nombre doit être inférieur à quoi pour être nommé une leucopénie :
4.5X109/L
Cette cellule a un diamètre moyen de 30 μm. Son cytoplasme est abondant et de couleur gris clair. Son noyau très volumineux est irrégulier ou réniforme. Sa chromatine est fine et prend un aspect peigné
- Monocyte
- Grand lymphocyte
- Granulocyte neutrophile
- Monocyte
Cette cellule a un cytoplasme acidophile rempli de grosses granulations rouge-orangé. Son noyau bilobé est presque recouvert par ces granulations. Son diamètre moyen est de 14 μm.
- Granulocyte neutrophile
- Granulocyte basophile
- Granulocyte éosinophile
3- granulocyte éosinophile
Cette cellule a un noyau rond parfois légèrement excentrique. Sa chromatine est dense et disposée en mottes foncées séparées par des zones plus claires. Son cytoplasme est bleu clair avec une basophilie plus nette à la périphérie.
- Monocyte
- Plasmocyte
- Grand lymphocyte
2-Plasmocyte
Cette petite cellule a un noyau occupant presque toute la cellule (9/10) et une chromatine très dense et disposée en blocs foncés. Son cytoplasme est peu abondant et basophile; il n’apparait souvent que d’un seul côté.
- Petit lymphocyte
- Granulocyte basophile
- Petit monocyte
1-Petit lymphocyte
Cette cellule a un noyau légèrement encoché et réniforme, une chromatine dense et un cytoplasme rose avec des granulations beiges ou marron.
- Myélocyte
- Métamyélocyte
- Stab neutrophile
2-Métamyélocyte
Cellule de forme arrondie et d’un diamètre de 12-14 μm. Le cytoplasme est acidophile et contient de fines granulations neutrophiles. Le noyau est non segmenté en forme de S et la chromatine est dense.
- Métamyélocyte
- Stab neutrophile
- Granulocyte neutrophile
2-Stab neutrophile
Grande cellule au noyau de forme ovale avec une chromatine fine. Les nucléoles sont peu visibles. Le cytoplasme faiblement basophile contient de grosses granulations rouge vineux.
- Promyélocyte
- Myélocyte
- myéloblaste
1-Promyélocyte
petite cellule de 9-10 μm avec un petit noyau rond pycnotique et un cytoplasme abondant orangé avec fond bleu-gris. La chromatine est disposée en bandes étroites non condensées.
- Petit lymphocyte
- Réticulocyte
- érythroblaste
3-érythroblaste
cette grande cellule a un rapport nucléolo-cytoplasmique élevé, une chromatine très fine, un cytoplasme basophile et de rares granulations azurophiles. On observe aussi plusieurs nucléoles (2-5) nettement apparents.
- Myéloblaste
- Myélocyte
- monocyte
1-Myéloblaste
cellule de forme arrondie avec un noyau difficile à distinguer à cause de nombreuses granulations bleues très foncées. Ces dernières sont très grosses, rondes ou ovales.
- Granulocyte neutrophile
- Granulocyte éosinophile
- Granulocyte basophile
3-Granulocyte basophile
Cellule d’environ 15-20 μm contenant un noyau rond ou ovale, une chromatine fine, nuageuse ainsi qu’un nucléole. Son cytoplasme très basophile est peu abondant, bien délimité et sans granulations
- Lymphoblaste
- Lymphocyte
- métamyélocyte
1-Lymphoblaste
Quel est le processus de diapédèse:
- Ils adhèrent aux parois endothéliales
- Un pseudopode s’infiltre entre les cellules endothéliales
- La cellule passe de l’autre côté
Chimiotactisme :
ce qui permet aux granulocytes de se déplacer dans une direction précise dépendamment si des substances les attirent ou repousse.
Il y a deux sortes de substances chimiotactiques :
- Cytotaxines : agissent directement sur les granulocytes
- Cytotaxinogènes : ont une action indirecte, qui va créer un facteur chimiotactique après son contact avec le sérum ou le plasma.
Étapes de la phagocytose
- Migration
- Diapédèse
- Opsonisation : traité à l’opsonine pour la rendre plus vulnérable à être ingéré par le phagocyte
- Marquage : le marquage d’un organisme pour l’ingestion
- Ingestion : formation d’une vacuole de phagocytose (phagosome) et dégranulation (libération du contenu des granules dans le phagosome).
- Bactéricide : destruction de la particule phagocytée
- Exocytose : digestion et rejet des produits de la digestion
Deux sortes de bactéricidie :
- Dépends de l’O2 : une explosion oxydative se passe sur les granulocytes activés et produit plusieurs composés oxydants toxiques
- Peroxyde d’hydrogène
- Anion superoxyde
- Radicaux hydroxyles
- Singulet d’O2
- Non dépendant de l’O2
- pH
- substances antimicrobiennes
- protéine cationiques
- phagocytine
- leukine
Cristaux de Charcot-Linden :
ils sont des produits de dégénération de la membrane des éosinophiles. C’est une indication que le nombre d’éosinophiles est élevé et que leur activité est aussi augmentée.
Sécrétion des éosinophiles:
- l’histamine
- l’héparine : liée au métabolisme des triglycérides
- FCE (facteur chimiotactique des éosinophiles) : libéré par les mastocytes tissulaires, ce facteur chimiotactique provoque la migration des éosinophiles. Les basophiles vont venir et eux aussi vont libérer le FCE.
- FAP (facteur activateur des plaquettes)
- Kallicréine : agit dans l’activation de la coagulation et de la fibrinolyse
composition des lymphocytes :
- acides nucléiques (ADN dans noyau, ARN dans noyau et cytoplasme)
- lipides (phospholipides, cholestérol, lécithine)
- glycogène (petite quantité) utilisé pour :
- glycolyse anaérobie
- voie des pentoses
- H2O (vaut 79% du poids les lymphocytes)
- électrolytes (Na+, K) (K 3 à 4 fois plus que le Na)
- enzymes
Quelle structure de mobilité est moins efficace
l’uropode est moins longs et plus épais, donc moins efficaces.
Rôle de la formule d’Arneth:
Donne un indice de la maturation des granulocytes neutrophiles.
Résultats de la formules d’Arneth:
- normal: 50% ont 3 lobes
- déviation à droite: hypersegmentation (+ que 5 lobes)
- déviation à gauche: hyposegmentation (- que 3 lobes)
Les leucopénies peuvent être causés par:
- insuffisance médullaire
- agranulocytose
- chimiothérapie
Qu’est ce qu’on observe pendant une réaction leucémoide:
- cellules immatures sans avoir de blastes
- on ne trouve pas de signes cliniques d’une leucémie
- on trouve toujours une autre maladie en même temps (infection, intoxication au mercure, brulure…)
Trois caractéristiques du lupus érythémateux disséminé:
- atteint du tissu conjonctif
- anticorps qui vont réagir contre les composants des noyaux cellulaires
- on retrouve des cellules LE
Types d’anomalies non malignes:
- anomalies de distribution
- lupus érythémateux disséminé
- anomalie morphologique acquise
- neutrophiles hypersegmentés
- lymphocytes anormaux
- cellule de Mott
- cellule de Reider
- Ombre de Gumprecht
- mononucléose infectieuse
- infection par cytomégalovirus
- anomalies héréditaires
- anomalie de Pelger-Huet
- maladie de Chediak-Steinbrink-Higashi
- anomalie de May-Hegglin
- maladie d’Alder-Reilly
- maladie de Hurler (gargoilisme)
- maladies de surcharge
- maladie de Gaucher
- maladie de Neiman-Pick
- Anomalies fonctionnelles
- granulopathies
- déficit immunitaire
6.
Quelle est la cause de cellule de Reider:
Artéfact causé par une réaction à l’oxalate ou EDTA ou que le spécimen est âgé.
Un nombre élevée d’ombre de Gumprecht peut indiquer:
Une leucémie lymphoide chronique
Mononucléose:
Infection fébrile causé par le virus d’Epstein-Barr
Anomalie de Pelger-Huet
Hyposegmentation des neutrophiles (en forme de lunettes dans certains cas).
Quelle est l’effet de l’anomalie de Pelger-Huet sur les globules blancs:
Il n’affecte pas la fonction ou la survie des globules blancs.
Maladie de Chediak-Steinbrink-Higashi
Ce sont des lysozymes anormaux qui viennent de la fusion des granules primaires et secondaires. Les cellules ont des altérations morphologiques et fonctionnelles.
Quelle est l’évolution de la maladie de Chediak
Age maximum de 10 ans surtout du aux infections et hémorragies.
Anomalie de May-Hegglin
Ce sont des plages basophiles (ressemble aux corps de Dohle) dans le cytoplasme des granulocytes et parfois des monocytes.
Quelles sont les caractéristiques des plaquettes durant l’anomalie de May-Hegglin:
- géantes
- hypogranulaires
- en nombre diminé
- les fonctions sont normales mais leur durée de vie est diminuée
Maladie d’Alder-Reilly
Ce sont des grosses granulations éosinophiles. Les granulations contiennent des muccopolysaccharides qui viennent du catabolisme incomplet des glucides.
Maladie de Hurler
Granulations ressemblant à celles de Alder-Reilley sauf qu’elles sont surtout retrouvées dans les lymphocytes, monocytes, plasmocytes et cellules réticulaires. Causé par une anomalie du métabolisme des polysaccharides.
Maladie de Gaucher
Première maladie lysosomiale curable, causé par une accumulation de glucocérébrosides.
Manifestation de la maladie de Gaucher
Pigmentation ocre de la peau chez les Juifs
Maladie de Neiman-Pick:
Déficit de sphingomyélinase qui cause une accumulation des sphingomyéline et cholestérol dans les cellules réticulohistiocytaires et les tissus.
Granulopathies
Un mal fonctionnement des globules blancs (surtout les neutrophiles).
Déficit immunitaire:
Un malfonctionnement des lymphocytes T ou B
Quel est le rapport normal de CD4:CD8:
2:1
Granulocytes neutrophiles dont le diamètre est plus grand que la normale et dont le noyau est multilobé :
neutrophile hypersegmenté
Lymphocytes ayant un cytoplasme hyperbasophile et des contours très irréguliers :
lymphocyte atypique
Plasmocytes remplis d’inclusions de type corps de Russell :
cellules de Mott
Ombres nucléaires résultant de bris lors de l’étalement :
ombres de Gumprecht
Lymphocytes dont le noyau a l’aspect d’un trèfle :
cellule de Reider
Noyaux nus très pâles abondants dans la leucémie lymphoïde chronique :
ombres de Gumprecht
Agrégats de réticulum endoplasmique :
corps de Döhle
Vacuoles composées de mucopolysaccharides et de gamma-globulines
corps de Russell
Grosses granulations violet pourpre trouvées dans le granulocyte neutrophile lors d’états infectieux aigus :
granulations toxiques
Inclusions rouge pourpre souvent rencontrées dans les leucémies myéloblastiques :
corps d’Auer
Vacuoles de taille variable trouvées dans les plasmocytes :
corps de Russel
Appendice nucléaire rattaché au noyau du granulocyte neutrophile par un fin filament de chromatine :
chromatine sexuelle
Amas de chromatine en forme de triangle trouvé seulement sur la membrane nucléaire des individus de sexe féminin :
chromatine sexuelle
Zones bleues à la périphérie du cytoplasme du granulocyte neutrophile lors d’états infectieux aigus :
corps de Döhle
Il y a principalement 4 étapes aux colorations spéciales :
- Fixation : permet de fixer les éléments sur la lame et d’assurer qu’ils ne seront pas modifiés pendant la coloration
- Réaction : dépendant du colorant utilisé, cette première coloration va mettre en évidence une certaine composante de la cellule par réaction cytochimique ou enzymatique
- Contre-coloration : permet de colorer les éléments non recherchés d’une couleur contraste à la réaction initiale et de faible intensité (pour éviter de masquer la réaction), ce qui facilite l’interprétation de la lame
- Interprétation : interprétation des lames par la combinaison des différentes colorations selon les paramètres recherchés, fait par un pathologiste
Réaction cyto-enzymologique (enzymatique) d’une coloration spéciale:
Réaction chimique qui est catalysée par un complexe enzyme-substrat.
Réaction cytochimique (non enzymatique) d’une coloration spéciale:
Basé sur les propriétés chimiques des éléments qu’on veut observer.
Quels points en commun ont les syndromes myéloprolifératifs:
- prolifération anormale d’une ou plusieurs lignées médullaires
- origine clonale de la maladie à partir d’une cellule souche commune (CFU-GEMM)
- transformation fréquente en leucémie myéloblastique ou lymphoblastique aigue
- fréquence élevée de thromboses vasculaires
- fibrose médullaire
Qu’est ce qu’un syndrome myélodysplasique:
Groupe hétérogène de maladies qui sont caractérisées par une hématopoièse inefficace donc défaut de maturation.
Les syndromes myélodysplasiques ont beaoucoup d’anomalies des:
Chromosomes
Quelle est le type d’anomalie de chromosome le plus souvent rencontré dans les syndromes myélodysplasiques:
Une variation dans le nombre de chromosomes (5,7 et 8 surtout)
Quels sont les classifications FAB des syndromes myélodysplasique:
- AR: anémie réfractaire
- ARSC: anémie réfractaire avec sidéroblastes en couronne
- AREB: anémie réfractaire avec excès de blastes
- AREBt: anémie réfractaire avec excès de blastes en transformation
- LMMoC: leucémie myélomonocytaire chronique
La classification des syndromes myélodysplasiques est faite selon:
- la présence et le % de blastes dans le sang et la moelle
- le nombre de monocytes dans le sang
Quels sont les principaux symptomes des syndromes myélodysplasiques:
- fatigue: dépen de la sévérité de l’anémie
- infections: dépend des taux de neutro
- hémorragies: dépend du taux de plaquettes
Quels sont les caractéristiques communs des syndromes lymphoprolifératifs:
- néoplasie malignes des cellules lymphoides ou plasmocytaire. Ces cellules proviennent d’un clone de cellules anormales
- ces cellules envahissent la moelle et le sang
- ces cellues peuvent sécréter des immunoglobuline anormales du type monoclonal
- leur évolution est souvent chronique
Comment les lymphomes sont-ils divisés
- 4 différents stades qui sont définis par l’emplacement des adénopathies
- stade I: implication d’un seul foyer ou de 2 foyers voisins du même côté du diaphragme
- stade II: implication de 2 foyers ou plus, qui ne sont pas voisins mais qui sont encore du même côté du diaphragme
- stade III: les foyers impliqués sont d’un bord et de l’autre de diaphragme, mais seulement dans les tissus lymphoides
- III1: atteinte seulement à la partie supérieure de l’abdomen (dessus de l’artère rénale)
- III2: atteinte au-dessous de l’abdomen
- stade IV: rendus dans la moelle ou autres organes, qu’il y ait ou non atteinte des ganglions
- divison entre A et B
- A: s’ils n’ont aucun symptômes général
- B: s’ils ont les symptômes généraux
- C: atteinte d’un organe non-lymphoide
- D: atteinte de la rate
- E: extra lymphatique
- S: splénique
L1, L2 et L3:
Leucémie lymphoblastique aigue
Quel leucémie contient des grosses granulations et plages:
Leucémie lymphoblastique aigue
Quelle maladie est associé avec le marqueur CD38
Leucémie à plasmocytes
M1 et M2
Leucémie myéloblastique
M3:
Leucémie promyélocytaire
M4:
Leucémie myélomonoblastique
Quel est le type de leucoblastes ans la leucémie lymphoblastique aigue:
Lymphoblastes
Type de leucoblaste dans la leucémie myéloblastique:
Myéloblastes
Particularité de la leucémie myéloblastique:
Corps d’Auer
Type de leucoblaste dans la leucémie promyélocytaire:
Myéloblaste
Quelle maladie est associé avec une translocation 15;17
Leucémie promyélocytaire
Type de leucoblastes dans la leucémie myélomonoblastique:
Myéloblastes et monoblastes
Quelle maladie est associé avec la translocation 6;9
Leucémie myélomonoblastique
M5a et M5b
Leucémie monoblastique
M6:
Érythroleucémie
M7:
Leucémie à mégacaryoblastes
Quel est le synonyme de la leucémie du type Schilling:
Leucémie monoblastique
Quels sont les cellules prédominantes de la leucémie monoblastique:
Monocytoides
Quelle est la différence entre M5a et M5b:
- M5a: les cellules sont indifférencier
- M5b: les cellules sont différencier
Quel est le type de leucoblaste dans l’érythroleucémie:
Érythroblastes
Quelle maladie est associé au marqueur CD33
Érythroleucémie
Quel est le type de leucoblaste dans la leucémie à mégacaryoblastes:
Mégacaryoblastes
Chez qui retrouve on surtout les syndromes myéloprolifératifs:
> 50 ans
Quelle est la lignée atteinte de la leucémie myéloide chronique:
Granulocytaire
Quelle est la particularité de la leucémie myéloide chronique:
Chromosome philadelphia présent dans 80% des cas
Quelle maladie est assoicé à la translocation 9;22
Leucémie myéloide chronique
Comment fait-on pour différencier les syndromes myéloprolifératifs:
La leucémie myéloide chronique est le seul avec un PAL diminué ou absent.
Quelle est la lignée atteinte de la myélofibrose idiopathique:
Granulocytaire et érythrocytaire
Quelle est la particularité de la myélofibrose idiopathique:
Hématopoièse extramédullaire
Quelle est la lignée atteinte de la thrombocythémie essentielle:
Mégacaryocytaire
Quelle est la particularité de la thrombocythémie essentielle:
Nombre excessif de plaquettes avec altération fonctionnel et morphologique.
Quelle est la lignée atteinte de la polyglobulie absolue primitive:
- érythrocytaire
- granulocytaire
- mégacaryocytaire
Quelle est le synonyme de la maladie de Vasquez:
Polyglobulie absolue primitive
Quelle est le syndrome myélodisplasique le moins sévère:
AR
quelle syndrome myélodysplasique est la plus fréquente:
AREB
Comment fait on la différence entre AREB-t et LMMoC:
Dans le sang:
- AREB-t: >5% de cellules blastiques
- LMMoC: <5% de cellules blastiques
Dans la moelle
- AREB-t: 20-30% de myéloblastes avec corps d’Auer
- LMMoC: <20% de cellules blastiques
Quels sont les particularités de la leucémie lymphoide chronique:
- noyaux ressemble à des tortues
- beaucoup d’ombres de Gumprech
Quels sont les particularités de la leucémie à tricholeucocytes:
- pancytopénie
- tricholeucocytes circulantes
Quels sont les particularités de la Macroglobulinémie de Waldenstrom:
- envahi d’autres tissus
- Dutch bodies
- prolifération de plasmocytes
- pic d’immunoglobuline M monoclonal dans le sérum
Quels sont les cellules dominantes dans la leucémie lymphoide chronique:
Petits lymphocytes
Quelles sont les cellules dominantes de la leucémie à tricholeucocytes:
tricholeucocytes
Quelles sont les cellules dominantes dans le myélome multiple:
plasmocytes en phase terminale
Quelles sont les cellules dominantes dans la macroglobulinémie de Waldenstrom:
Lymphes
Quel est le principe du test de corps de Heinz:
Mise en évidence par des colorants vitaux ou provoquer leur formation par l’addition d’un agent oxydant.
Quel est l’utilité du test de falciformation:
Permet de détecter et d’identifier l’hémoglobine S
Quel est l’utilité du test de Schilling:
Pour déterminer si le tractus digestif est capable d’absorber un montant adéquat de vitamine B12 pour maintenir une bonne santé.
Quels sont les résultats du test de Schilling:
- vitamine B12 dans l’urine; présence du facteur intrinsèque, vitamine B12 a été absorbé
- vitamine B12 dans les selles: il n’y a pas de facteur intrinsèque car la vitamine B12 n’a pas été absorbé. Peut être causé par un manque de FI ou une malabsoprtion du B12
Quel est l’utilité du test de Ham:
Pour le dépistage de HPN
Quel est le principe du test de Ham:
Les GR des patients ont une grande sensibilité à l’action hémolysante du complément activé.
Quel est le résultat du test de Ham:
Présence de lyse indique une faible résistance des globules rouges.
Quel est l’utilité du test de Donath-Landsteiner:
Pour le dépistage du HFP
Quel est le principe du test de Donath-Landsteiner:
- causé par une auto-hémolysine IgG
- contrôle est placé à 37oC
- le patient est placé à 4oC et ensuite à 37oC
Quels sont les résultats du test de Donath-Landsteiner:
- test positif: controle a aucune hémolyse et le patient a de l’hémolyse
- test négatif: le controle et le patient n’a aucune hémolyse
- test non concluent: le controle et le patient a de l’hémolyse
Hémoglobine Portland:
Zêta2, gamma2
Hémoglobine Gower I:
Zeta2, epsilon2
Hémoglobine Gower II:
Alpha2, epsilon2
Hgb adulte:
Alpha2, bêta2
Hgb A2
Alpha2, delta2
Hgb foetale:
alpha2, gamma2
Anomalie de l’hémoglobine S:
On ajoute du sang à un agent réducteur (métabisulfite de na) et on empêche le contact avec l’oxygène.
Hémoglobine C:
Formation de cristaux lorsque la cellule est déshydratée
Quelle maladie présente des cellules Reed-Sternberg:
Lymphome Hodgkin